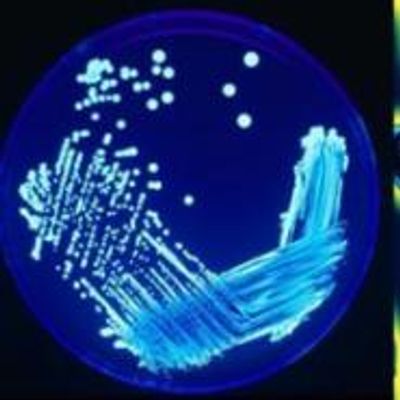

Beacon Water Treatments Limited products
Triplex - Aerator Systems for Iron and Manganese Removal
When rain falls, the water has a naturally aggressive, slightly acidic nature. This water then dissolves chalk and/or metallic deposits present in the local rock strata which contaminates the water. This results in ground and borehole water containing a number of elements that would not normally be present in mains water. These contaminants (such as Iron and Manganese) then cause problems when the water is put to use.
Towertech - Model 5000 - Controller
The controller provides TDS Bleed & inhibitor dosing with Bromine & Biocide dosing. Two lockouts are provided for bleed (0-1 hour) and one hour fixed lockout to the bromine activated by the biocide pump.
Towertech - Model 4000 - Controller
Provides TDS conductivity bleed control, Dual Biocide with 15-1 ratio facility, proportional inhibitor Dosing, 0-6 bleed lockout timer activated by either biocide pump. Both manual override switches & time adjustments to all outputs on the facia plate of controller.
Towertech - Model 3000 - Electronic Dosing System
Due to the advance in recent years of both electronic and chemical technology, it has become apparent that today`s Water Treatment professional requires a single controller developed to suit most water treatment applications, where TDS conductivity control is not required. The Towertech 3000 has been developed for this purpose to finally give a choice to the Chemical industry, with Dual Biocide, Proportional Bleed and inhibitor dose, with a 0-6 hr bleed lock out timer as standard this controller is unique in its design.
Towertech - Model 2000 - Conductivity Controller
The Towertech 2000 Controller is a simple to install and operate unit. With a single set point the unit can be used for the following applications:
Towertech - Model 1001 - Proportional Timer Controller
The controller provides two timed outputs for bleed & dose control on cooling towers, both output times are adjustable and override switches with integral led are mounted on the front of the controller, indication of pulse signal from the water meter is confirmed through the red LED mounted.
Towertech - Model 1000 - Proportional Timer Controller
The controller has a single timed output suitable for bleed control or dosing of chemicals on many water treatment applications, the output time is adjustable and a override switch with integral red led is mounted on the front of the controller.
Beacon - Ozone Purification System
Ozone is an extremely powerful oxidising agent, a very reactive but odourless gas that occurs naturally in the earth’s atmosphere. Due to the unstable nature of the Ozone molecule (it contain three oxygen atoms as opposed to the two found in normal Oxygen) it reacts readily with other species. This can be used to good effect in the treatment of contaminated water. Ozone needs energy to trigger its formation, being created by the effect of sparks or ultra-violet light on Oxygen in the air.
Beacon - pH Correction System
When rain falls, the water has a naturally aggressive, slightly acidic nature. This water then dissolves chalk and/or metallic deposits present in the local rock strata which leads to contamination of the water. This results in ground and borehole water containing a number of elements that would not otherwise be present in mains water. These contaminants (such as iron and manganese) then cause problems when the water is put into use.
Beacon - Model EP Series - Carbon-Briquette Cartridge
High dirt-holding tolerance maximizes utilization of the carbon block Greater chlorine removal capacity than competitive 10-micron carbon blocks Nominal 5-micran rating.